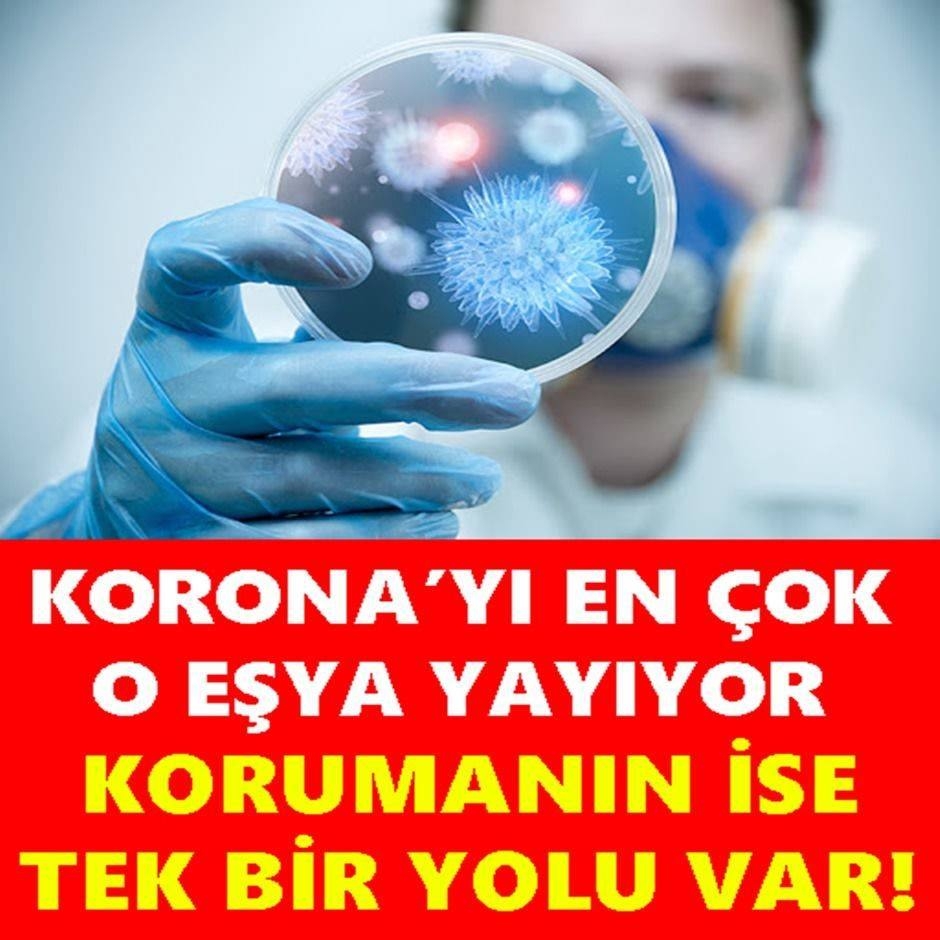

KORONAYI EN ÇOK O EŞYA YAYIYOR
12 Aralık 2020 Cumartesi 16:51Prof. Dr. Nurcan Baykam, yeni K-1-9ü s-algınına karşı alınması gerekli olan önlemlerle ilgili önemli öneri ve ikazlarda bulundu.
Tüm Hakları Saklıdır © 2014 Haberdarım | İzinsiz ve kaynak gösterilmeden yayınlanamaz.
Haber Yazılımı: So Bilişim
Haber Yazılımı: So Bilişim